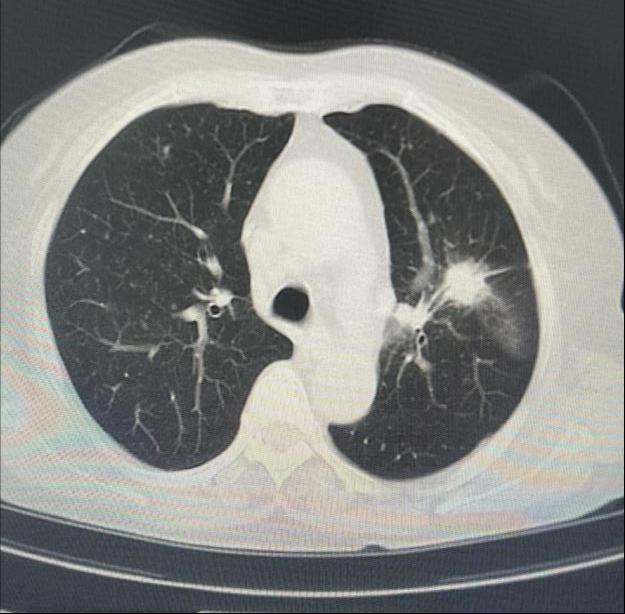
C260

近日,乐鱼在线登录入口呼吸内镜诊疗中心,成功开展4例小超声支气管镜冷冻肺活检术,此项技术在肺外周病变诊断中发挥着重要作用。

患者女性,因“气短1月”来门诊就诊,为明确诊断进一步治疗,收入乐鱼在线登录入口。入院后完善相关检查,胸部CT示左肺上叶前段高密度灶,与家属充分沟通后,决定为患者行超声支气管镜检查。主任医师吴水淼与主管护师薛冬冬为患者行气管镜检查,镜下示:双肺支气管均未见明显异常,结合CT给予超声探查,于左肺上叶前段亚支探及偏心异常回声区,由于亚支位置较高且管腔较窄,活检钳无法到达,给予冷冻肺活检。此次检查过程顺利,成功获取2块活检标本,活检病理结果提示为粘液腺癌。


患者,女性,于10天前无明显诱因出现咳嗽,干咳为主,未予以重视,之后仍咳嗽、咳痰,就诊于外院,胸部CT提示双肺纹理增粗、右肺门团块影、右肺下叶前基底段实性结节团。为求进一步诊治转入我院乐鱼在线登录入口。入院后完善相关检查,于10月17日9时安排气管镜检查,副主任医师韩蓓与主管护师薛冬冬为患者行气管镜检查,镜下示:双肺支气管均未见明显异常,结合CT给予超声探查,于右肺下叶前基底段亚支探及偏心异常回声区,由于亚支位置较远且管腔较窄,活检钳无法到达,给予冷冻肺活检,成功获取3块活检标本,活检病理结果提示为恶性肿瘤。
经支气管冷冻肺活检是将冷冻探针经支气管镜工作通道伸入到目标病灶内,利用冷冻探针的粘附力获取病变组织的一项诊断技术。该项技术经自然腔道,安全性高,操作简单,诊疗效率高,同时也可克服传统钳夹活检组织标本小、部分位置难以到达的问题。同时,冷冻技术还可用于狭窄再通、气道内异物摘除、坏死组织及血凝块的去除等。